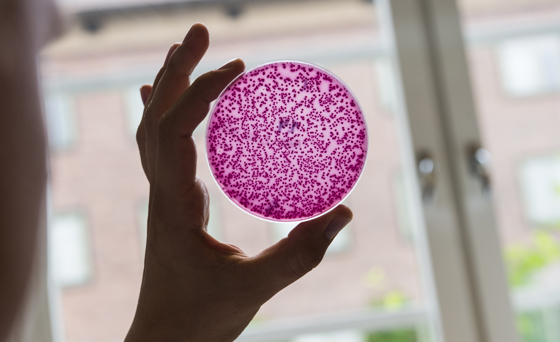
Veterinærinstituttet har fått EU-midler for å arbeide med forebygging og bekjempelse av antibiotikaresistens gjennom JPIAMR-programmet.

Veterinærinstituttet er med i stort EU-prosjekt om antibiotikaresistens
Historisk arkiv
Publisert under: Regjeringen Solberg
Utgiver: Landbruks- og matdepartementet
Nyhet | Dato: 13.12.2017
Veterinærinstituttet har fått EU-midler for å undersøke hvordan antibiotikaresistens kan forebygges, kontrolleres og bekjempes. Instituttet er med i et samarbeidsprosjekt som ledes av Sveriges lantbruksuniversitet og involverer partnere fra flere land.
Land med voksende økonomier, økende befolkning og inntekt fremmer en utvikling med intensivering av husdyrproduksjonen. Forbruket av antibiotika øker, og antibiotikaresistente bakterier sprer seg fra produksjonsdyr til mennesker og miljø. En betydelig del av antibiotikabruken i verden skjer i grise- og fjørfeproduksjonen i Asia.
Veterinærinstituttet skal bruke svineproduksjonen i Thailand som et case, og teste tiltak som kan bidra til å redusere antibiotikabruken ved hjelp av datasimuleringer. Noe av forarbeidet består i å kartlegge og dokumentetere hva slags kunnskap og holdninger svinerøkterne har, hvordan svineproduksjonen foregår i praksis og hvordan produksjonen er organisert, styrt og ledet. Data om hvor svineproduksjonen foregår og er spredd og i hvilken størrelse er også en viktig del av dette forarbeidet. Veterinærinstituttet skal analysere prøver fra gris, bønder, og mennesker for å få mer kunnskap om overføringen av resistente bakterier mellom dyr, menneske og miljø.